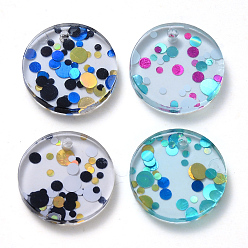
(52) Непрозрачная лаванда Подвески из ацетата целлюлозы (смолы), с пайеткой / пайетками, плоско-круглые, разноцветные, 13.5x2~3 мм, отверстие : 1.6~1.8 мм

Вы находитесь на нашей {0} станции. Вы также можете посетить наш сайт www.pandawhole.com{3} на {1} языках, чтобы получить более удобные условия для покупок.

Вы находитесь на нашей {0} станции. Вы также можете посетить наш сайт www.pandawhole.com{3} на {1} языках, чтобы получить более удобные условия для покупок.
15% скидка от US $149.00 18% скидка от US $699.00 21% скидка от US $1,599.00
От: US $0.05 / шт.
Время на Подготовку: 15-30 Дня
MOQ: 10 Упаковки (=2000 шт.)
Небольшие отклонения в цветах возможны из-за различий в устройствах отображения.
дюйм
см
Успешно добавить в корзину
Не удалось добавить!
Достигнуто максимальное значение 3,000.
{0} товара всего: 0
06 (52) Непрозрачная лаванда
SKU: KY-S161-002
MOQ: 10 Упаковки (2000 шт.)
Случайное Смешение
US $13.66
US $10.77
Опт
Подвески из ацетата целлюлозы (смолы), с пайеткой / пайетками, плоско-круглые
Поиск по изображению
![]()
2. Вставьте изображение Ctrl/Cmd + V